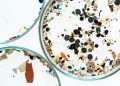
Microplastic Consumption

Jakarta, Indonesia Sentinel — At least 200 people were killed across Thailand during the annual Songkran festival, which took place from April 11 to 16, 2025, with Bangkok reporting the highest death toll.
“Two hundred lives were lost in traffic accidents during Songkran celebrations from April 11 to 16,” said Thailand’s Deputy Interior Minister Kachorn Srichavanothai during a press briefing.
According to Kachorn, the high number of deaths occurred due to the road accident during the festivities. A total of 1,377 road accidents were recorded during the week, resulting in 1,362 injuries.
While tragic, this year’s numbers mark a slight improvement compared to last year’s festival week, which saw 243 fatalities and 1,837 injuries from 1,811 reported accidents.
As in previous years, motorcycle crashes made up the majority of the incidents, accounting for more than 83% of total accidents. The primary causes were drunk driving and speeding.
On the final day of the holiday, April 16, authorities reported 155 accidents, 22 deaths, and 149 injuries. Lampang province recorded the highest number of crashes and injuries that day, with speeding cited as the most common cause.
From April 11 to 16, the southern province of Phatthalung reported the most traffic accidents overall, with 52 cases. Northern Lampang had the highest number of injuries at 56, while Bangkok topped the fatality count with 16 deaths.
Read Also:
Massive Sandstorm Sweeps Across Iraq, Sends Over 3.700 People to Hospitals Due to Respiratory Issues
Songkran, the traditional New Year festival celebrated by Theravada Buddhists in Thailand, is widely known for its street-wide water fights using buckets, hoses, and toy water guns. Despite its festive spirit, the holiday week alongside the Western New Year period is often dubbed Thailand’s “Seven Dangerous Days” due to the spike in road accidents.
Wednesday marked the official end of the Songkran public holiday, with heavy traffic expected as travelers returned to Bangkok and other major cities.
Chakree Bamrungwong, Inspector General of Thailand’s Ministry of Transport, said more people used public transportation this year compared to previous years. To accommodate the surge in demand, the ministry increased the number of buses, trains, and flights, while also implementing safety measures to help ensure a secure journey for travelers.
(Raidi/Agung)